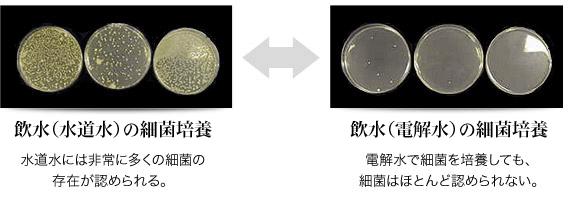
画像

痛みを感じないほどに
「進化」した虫歯治療
- 「削りすぎない」治療
- 「神経を取らない」治療
- 「歯を抜かない」治療


このページをご覧になっている方の中には、虫歯は「痛いもの」と考えている方がたくさんいらっしゃると思います。
しかし、「虫歯もつらいが、歯医者での治療はもっと痛い」と、歯医者に行くのに二の足を踏んでいる方もいることでしょう。
以前の歯医者での治療では、そういうところがあったかもしれません。
しかし、現在は治療技術も進歩して、虫歯の治療程度であれば、「ほとんど痛くない」が常識になりつつあります。
虫歯のまま放っておくと、虫歯はさらに進んで痛みもひどくなるだけでなく、治療が複雑になり、費用もかかってしまいます。
虫歯を治すには、早めの治療をおすすめします。
お子様からご高齢の方、ご来院いただいた全ての患者さんに安心して治療を受けていただけるよう、本町歯科診療所では、次の取り組みで治療の痛みを軽減しています。

治療の痛みは、麻酔注射で抑えます・しかし注射自体が苦手だという患者さんも少なくありません。
当院では、針を刺する位置に「表面麻酔」をかけ、麻酔が効いてから注射するので、注射の痛みはほとんどありません。

針が細ければ細いほど、痛みを感じにくくなります。
当院では医療機関向けに販売されている注射針の中で、もっとも細い針を利用しています。

麻酔液が冷たいと、その冷たさが刺激になり痛みを感じやすくなります。
当院ではカートリッジウォーマーと呼ばれる装置を使い、麻酔液を人肌と同じくらいの温度にしてから使用しています。

麻酔液の注入スピードが一定でないと痛みや不快感を引き起こしてしまうことがあります。
当院では、一定の速度で注射できる「電動注射器」を使っています。
痛みや不快感を軽減することができます。

口の中にも、痛みを感じやすい部分と感じにくい部分があるのです。
当院の医師は、その部位を見極める技術を身につけています。痛みを感じにくい部分を狙って麻酔を注射します

歯を削るドリルの振動や音が不快だという方は少なくありません。
当院では、振動や不快音の少ない「5倍速コントラ」というドリルを使っています。
患者さんのストレスを軽減につながっています。

一般的には、歯医者の治療が終わるまでに何度か来院していただくことになります。しかし、仕事や家事、育児などで忙しい方にとっては、何度も歯医者に通う時間を作るのは難しいことがあります。
こうした方にお勧めしているのが、「短期集中治療」です。1回の治療時間を長く確保し、通常は何度かに分けて行う治療を1回でまとめて済ませることで、全体の治療期間を短縮します。
短期集中治療をご希望の方は、予約の際にお知らせください。
虫歯の治療の主流といえば、ドリルで大きく歯を削った上で、被せ物をする治療というものでした。
しかし大きく削るという作業で健康な部分まで削ってしまうと、虫歯が再発した際には削れる部分がなくなってしまい歯の寿命を大きく縮めてしまっていました。
そのため当院では、可能な限り「削りすぎない」治療を心がけています。
当院の「削りすぎない」取り組みをご紹介します。

当院では「う蝕検知液」という、虫歯の部分だけを着色する検査薬を使用しています。
健康な部分には反応しないため、着色部分だけを削り、健康な部分を残すことができます

初期虫歯は熟練のドクターでも判別が難しいケースで活躍するのが、「ダイアグノデント」です。
・早期発見で虫歯の拡大を防ぐ
・虫歯ではない歯を誤って削ることを回避
・虫歯の取り残しがないか確認しやすい
などのメリットがあります。

多くの歯科医院では、歯が痛い場合には、「神経を取る」治療を当たり前のように行っています。しかし、歯の神経には歯に栄養を届ける「血管」も含まれているのです。
神経を失った歯は、栄養を取り入れることができなくなり、徐々に歯がもろく、弱くなってしまいます。
そのため、歯を長持ちさせるためにも、可能な限り神経は取らないのがよい治療法といえます。
当院で行っている「神経を取らない」取り組みについて、ご紹介していきます。

虫歯を削ってできた穴の部分に、「MTAセメント」という充てん材を詰めます。
この充てん材は殺菌性に優れ、患部の虫歯菌を退治してくれるのです。
密閉性にも優れており、細菌が侵入して虫歯が再発するのを防ぎます。

虫歯が神経の近くまで到達してしまった場合には、「覆髄法」という治療を行います。
神経(歯髄)を覆う治療法で、虫歯に感染した部分だけを削って取り除き、MTAセメントを詰める方法です。
症状によっては、虫歯を削ると神経が露出してしまうことがありますが、MTAセメントで直接神経を覆うことで、神経を残せるケースもあります。

虫歯が神経に到達して、神経が炎症を起こしてしまうと、多くの場合は神経を取る必要があります。
しかし、炎症の程度などによっては、「断髄法」という治療法で、神経を残せるケースもあります。
断髄法では、炎症を起こした部分だけを取り除き、「覆髄法」と同じようにMTAセメントで覆うことで残された神経を保護します。

虫歯や歯周病などがひどく進行してしまった場合、抜歯と診断されることがあります。
歯を抜いた後は、一般的に「入れ歯」「ブリッジ」「インプラント」などの治療を行いますが、これらの治療法患者さんにとって負担が小さいものではありません。嚙み心地や機能性なども、ご自身の天然歯には及びません。
本町歯科診療所では、可能な限り「歯を抜かない」治療に取り組んでいます。
※すべての抜歯を避けられるものではありません。抜歯が最善の選択となることもあります。
以下、詳しくご紹介します。

写真のようにひどく虫歯が進行してしまった場合は、抜歯の確率が高くなってしまいます。歯を削って被せ物を装着するのが虫歯治療の基本的な流れですが、歯がひどく崩壊してしまうと、虫歯を削ったとしても被せ物を取り付ける場所が残っていないためです。
しかし、「エクストリュージョン」を活用することで、抜歯を回避できる可能性も出てきます。
この方法は歯根廷出術とも言い、矯正治療の1つです。
まず歯茎の下にある虫歯を、歯茎の上に露出させます。
そうして「土台」を立てることで、被せ物が可能になります。

虫歯がひどく進行して歯の神経が炎症を起こすと、「根管治療」を行い、神経を取り除きます。
神経を取り除いた歯に炎症が再発すると、歯の根の周囲に膿の袋ができます。
炎症の程度によっては、通常の交感治療では対応できず、抜歯となってしまうことがあります。
当院では、「歯根端切除術」という術式で抜歯せずに直せる場合があります。
歯根端切除術は、歯茎を外側から切り開き、歯の根の先端と膿の袋をまとめて取り除きます。
取り除いた後にできる空洞は血液で満たされ、いずれ骨が再生されます。


虫歯は口の中の「虫歯菌(細菌)」による感染症が原因です。
再発させないためには、徹底した除去・殺菌が重要なのです。
当院では、虫歯菌に対して強い殺菌力を持つ「殺菌水」を利用しているので、治療後の再発を抑えることができます。
殺菌水を「使用前」と「使用後」の状態を特殊な顕微鏡で撮影し、比較したものです。
殺菌水を使用すると、細菌はほとんどが死滅します。
当院では、患者さんが抱えていらっしゃるお口のお悩みや疑問・不安などにお応えする機会を設けております。どんなことでも構いませんので、私たちにお話ししていただけたらと思います。
ご興味がある方は下記からお問い合わせください。